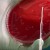

El 18, V Carrera del Día del Médico “Por la donación de órganos”
08/10/2015 · No comments
El domingo 18 de octubre se llevará a cabo en esta ciudad capital la V…
Realizan 2 mil 842 verificaciones de saneamiento básico
07/10/2015 · No comments
Con el fin de contribuir a la contención del dengue y chikungunya en el estado,...
INDICAS: Mejora calidad de servicios en SSA de Colima
06/10/2015 · No comments
La Secretaría de Salud y Bienestar Social del Gobierno del Estado informó que de acuerdo...
HAN SIDO ATENDIDAS MEDIANTE LAS BRIGADAS MÉDICO-ASISTENCIALES EN EL 2015
05/10/2015 · No comments
La administración municipal 2012-2015 en coordinación con el DIF que preside Leticia Contreras de Rangel,...
OPD: Contiene Salud los embarazos en adolescentes
04/10/2015 · No comments
En los hospitales de la Secretaría de Salud y Bienestar Social del Gobierno del Estado...
Un científico ruso se siente más fuerte y sano tras inyectarse la bacteria de ‘la vida eterna’
01/10/2015 · No comments
Anatoli Brushkov, jefe del Departamento de Geocriología de la Universidad Estatal de Moscú, asegura que...
Benefician a 49 colimenses más con programa “Para sentirme mejor”
30/09/2015 · No comments
Con el programa “Para sentirme mejor” del Patronato de la Beneficencia Pública de la Secretaría...
Médicos británicos realizan revolucionaria operación para curar la ceguera
30/09/2015 · No comments
Rt Actualidad.- Los cirujanos del Moorfields Eye Hospital de Londres realizaron la operación pionera en...
Reorientará Salud atención de enfermedades crónicas
29/09/2015 · No comments
La Secretaría de Salud y Bienestar Social del Gobierno del Estado desarrollará un modelo de...
Chikungunya tiene presencia ya en 21 estados del país
29/09/2015 · No comments
La fiebre por chikungunya ya se encuentra en 21 de las 31 entidades federativas de...